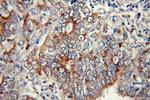
Calpain 9 Antibody in Immunohistochemistry (Paraffin) (IHC (P))

Search
Proteintech
Calpain 9 Polyclonal Antibody
{{$productOrderCtrl.translations['antibody.pdp.commerceCard.promotion.promotions']}}
{{$productOrderCtrl.translations['antibody.pdp.commerceCard.promotion.viewpromo']}}
{{$productOrderCtrl.translations['antibody.pdp.commerceCard.promotion.promocode']}}: {{promo.promoCode}} {{promo.promoTitle}} {{promo.promoDescription}}. {{$productOrderCtrl.translations['antibody.pdp.commerceCard.promotion.learnmore']}}
产品信息
17556-1-AP
种属反应
已发表种属
宿主/亚型
分类
类型
抗原
偶联物
形式
浓度
规格
纯化类型
保存液
内含物
保存条件
运输条件
产品详细信息
Immunogen sequence: ESEARTPFG LIKGHAYSVT GIDQVSFRGQ RIELIRIRNP WGQVEWNGSW SDSSPEWRSV GPAEQKRLCH TALDDGEFWM AFQDFKAHFD KVEICNLTPD ALEEDAIHKW EVTVHQGSWV RGSTAGGCRN FLDTFWTNPQ IKLSLTEKDE GQEECSFLVA LMQKDRRKLK RFGANVLTIG YAIYECPDKD EHLNKDFFRY HASRARSKTF INLREVSDRF KLPPGEYILI PSTFEPHQEA DFCLRIFSEK KAITRDMDGN VDIDLPEPPK PTPPDQETEE EQRFRALFEQ VAGEDMEVTA EELEYVLNAV LQKKKDIKFK KLSLISCKNI ISLMDTSGNG KLEFDEFKVF WDKLKQWINL FLRFDADKSG TMSTYELRTA LKAAGFQLSS HLLQLIVLRY ADEELQLDFD DFLNCLVRLE NASRVFQALS TKNKEFIHLN INEFIHLTMN I (178-627 aa encoded by BC027993)
靶标信息
Calpains are ubiquitous, well-conserved family of calcium-dependent, cysteine proteases. The calpain proteins are heterodimers consisting of an invariant small subunit and variable large subunits. The large subunit possesses a cysteine protease domain, and both subunits possess calcium-binding domains. Calpains have been implicated in neurodegenerative processes, as their activation can be triggered by calcium influx and oxidative stress. The protein encoded by this gene is expressed predominantly in stomach and small intestine and may have specialized functions in the digestive tract. This gene is thought to be associated with gastric cancer. Multiple alternatively spliced transcript variants encoding different isoforms have been found for this gene.
仅用于科研。不用于诊断过程。未经明确授权不得转售。
生物信息学
蛋白别名: Calpain-9; Digestive tract-specific calpain; GC36; nCL-4; New calpain 4; novel calpain large subunit-4; Protein CG36; unnamed protein product
基因别名: 2200003B16Rik; CAPN9; GC36; Ncl-4; NCL4
UniProt ID: (Human) O14815, (Mouse) Q9D805, (Rat) O35920
Entrez Gene ID: (Human) 10753, (Mouse) 73647, (Rat) 116694